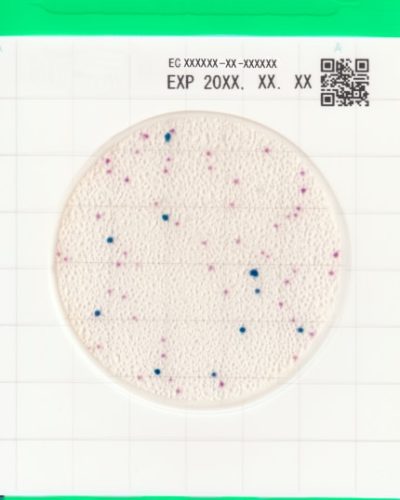
Easy-Plate-EC

EASY PLATE EC
E.coli ve E.coli olmayan koliformların saptanması, tanımlanması ve sayılması için özel besiyeri
E. coli ve koliformların tespiti, tanımlanması ve sayımı için AOAC sertifikalı özel hazırlık ve sterilizasyon gerektirmeyen, hazır ve steril bir besiyeridir. E.coli mavi koliformlar ise kırmızı renkte 24 saatte kolayca tanımlayıp saymanızı sağlar. Kolonilerin belirgin renkleri, gıda ve su testlerinde sık karşılaşılan etkileşimlerin üstesinden gelmeye yardımcı olarak E. coli ve koliformların test edilmesini ve sayımını kolaylaştırır. Easy Plate EC, AOAC sertifikalıdır ve her biri 25 test içeren 4 ayrı poşette 100 testlik paketler halinde satılmaktadır. 2-8°C arasında saklanır ve uzun raf ömrüne sahiptir.
